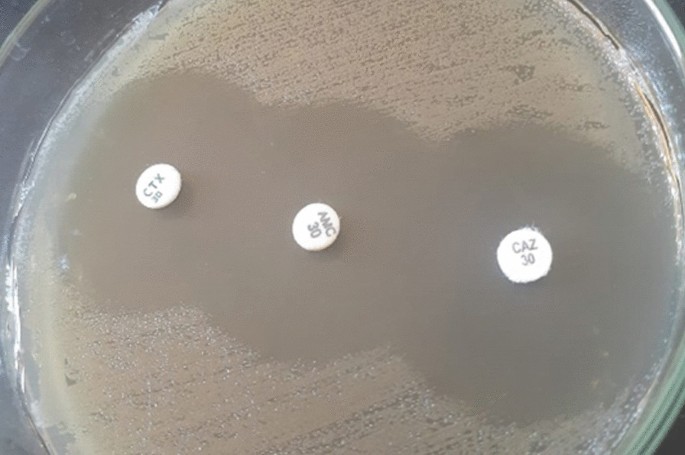
figure 5

- Research
- Open access
- Published:
Combination of silver nanoparticles with ineffective antibiotics against extended spectrum beta-lactamases producing isolates at Alexandria Main University Hospital, Egypt
Beni-Suef University Journal of Basic and Applied Sciences volume 10, Article number: 58 (2021)
Abstract
Background
The context and purpose of the study: The spready dissemination of resistance mechanisms among extended spectrum beta-lactamases (ESBL) producing bacterial isolates has increasingly been reported. There is an urgent need to explore the antibacterial property of nontoxic biosafe compounds. This In-vitro experimental study aimed to evaluate the effect of silver nanoparticles (AgNPs) alone and in combination with ineffective antibiotics against ESBL producing isolates.
Results
Ciprofloxacin with AgNPs combination had the highest synergistic percentage against 91.43% of ESBL Escherichia coli isolates, and it was additive against 8.57% of them. As regards ESBL K. pneumoniae isolates, AgNPs with cefotaxime were synergistic against 75.00% of them, followed by ceftazidime and ciprofloxacin (62.50%). The least effective combination was ampicillin with AgNPs. The greatest enhancement of activity of the antibiotics was observed at silver minimum inhibitory concentration (MICAg) MICAg/2 and MICAg/4. At lower AgNPs concentrations, enhanced effects were less obvious. AgNPs inhibited the production of beta-lactamase enzymes in 91.43% of E. coli and 75% of Klebsiella pneumoniae isolates.
Conclusion
AgNPs are a valuable alternative to combat drug resistance, as they had synergistic effects when combined with different ineffective antibiotics against ESBL producing bacteria. AgNPs had lowered MIC values of antibiotics by several folds. Moreover, they inhibited the production of beta-lactamase enzymes.
1 Background
Extended-spectrum beta-lactamases ESBL bacteria are often acquired through transferable plasmids which carry genetic information that code for resistance determinants to different antibiotic classes. Widespread dissemination of infections caused by multi-drug resistance ESBL (MDR-ESBL) bacteria is a major public health problem due to limited curative options [1].
These infections require the administration of high doses of antibiotics which may lead to intolerable toxic and adverse effects. Moreover, massive economic investment is required for the development of new antibiotics. Studying the unconventional antimicrobial effects of novel agents is necessary to develop alternative antimicrobials to overcome the problem of MDR-ESBL bacteria. Nanotechnology is a promising alternative for developing novel antimicrobial compounds [2]. Nanoparticles (NPs) are regarded as the next-generation of antibiotics. AgNPs exert their broad-spectrum antibacterial activity through direct contact with the bacterial cell wall, without penetration the cell. The large surface-area-to-volume ratio of NPs increases their contact area with microorganisms [3]. They can target multiple biomolecules leading to enzymatic inhibition, protein deactivation, DNA damage, bacteria wall disruption, as well as changes in gene expression [4]. AgNPs had been used in combination with antibiotics to improve their antimicrobial activities (synergistic effect). AgNPs concentrate the antibiotics at the site of action and thus improve their potency, reduce the need for high dosages of antibiotics and minimize their side effects. AgNPs proved to be synergistic when combined with chloramphenicol, ampicillin and amoxicillin [5, 6]. However, antagonistic interaction of AgNPs with amoxicillin or oxacillin had been reported [7]. To our knowledge, there is limited research on the antibacterial activity of AgNPs against ESBL bacteria in Egypt. This study may provide clarification of either synergistic or antagonistic effects of AgNPs on ESBL bacteria. This In-vitro experimental study aimed to evaluate the effect of silver nanoparticles (AgNPs) alone and in combination with ineffective antibiotics against ESBL producing isolates.
2 Methods
2.1 Study area
This in-vitro experimental study was carried out during the period from October 2019 to October 2020. The study protocol was approved by the Ethics Committee at the High Institute of Public Health (HIPH), and an informed consent was obtained from each patient.
2.2 Sampling
An interview questionnaire sheet was filled for each patient including all relevant information (age, sex, type of surgical wounds, duration of skin wound or burn, current or previous use of urinary catheters, recurrent symptomatic UTIs, antibiotics treatment and history of hospitalization). All inpatients and outpatients with UTIs, skin and wound infections were included (as these are the most common infections caused by ESBL bacteria) with no exclusion criteria. Most of the patients were females. Patients age range were from 16 > 51 years.
The minimal sample size was calculated based on a previous study that aimed to detect AgNPs enhancement of the bactericidal activity of inactive antibiotics against multiresistant Enterobacteriaceae, which reported a mean FIC of antibiotic in combination with different AgNPs concentrations of 0.4 with standard deviation of 0.1. By using precision of 0.03 and confidence interval of 95%, the minimum required sample size is 43 ESBL isolates.
The study enrolled ESBL producing E. coli and K. pneumoniae isolates from 43 clinical samples obtained from patients attending or admitted to main hospital with different types of infections (urinary tract, wound and burn skin infections).
2.3 Laboratory investigation
2.3.1 Processing of samples
2.3.1.1 Swabs from infected wounds and burns
Swabs were inoculated on blood agar (BA) (Himedia M144) and MacConkey’s agar plates (Himedia M081).
2.3.1.2 Urine samples
A standard calibrated loop 10 µl (0.01 ml) was inserted vertically in the well-mixed uncentrifuged urine and was then streaked over the surface of well dried CLED agar plate (Himedia M792).
2.3.2 Identification procedures
All isolated colonies were identified according to the standard microbiological procedures following their morphology in Gram stain, cultural characteristics and biochemical properties [8].
2.3.2.1 Wound and burn isolates
Isolates that appeared as medium sized, circular, grayish colonies, smooth, either hemolytic or non-hemolytic on BA plates, pink lactose fermenter (LF) on MacConkey's agar plates and appeared microscopically as gram negative bacilli were considered as members of Enterobacteriaceae.
2.3.2.2 Urine isolates
Oxidase negative isolates that appeared microscopically as gram negative bacilli and appeared as opaque yellow colonies with slightly deeper yellow center on CLED agar were considered as E. coli. Isolates that appeared as large yellow to whitish-blue and extremely mucoid colonies on CLED agar were considered as K. pneumoniae.
2.3.3 Detection of ESBLs production among E. coli and K. pneumoniae isolates by double-disk synergy test (DDST)
A lawn culture of each isolate was made on MHA plate, as recommended by CLSI. A disc of amoxicillin-clavulanic acid (20/10 μg) was placed in the center of the plate at 20 mm distance to ceftazidime 30 μg (CAZ) and cefotaxime 30 μg (CTX) (Bioanalyse, Turkey). ESBLs production was detected by the appearance of keyhole effect toward clavulanic acid disc due to the enhanced activities of ceftazidime and cefotaxime [8].
2.3.4 Determination of MICs of ineffective antibiotics by broth microdilution method
MICs of ineffective antibiotics and AgNPs were determined by broth microdilution assay [9, 10]. Antibiotic dilutions were prepared using Muller Hinton broth to get a concentration range between 128 and 0.25 µg/ml for ampicillin, cefotaxime and ceftazidime, and between 32 and 0.06 µg/ml for ciprofloxacin. A stock AgNPs solution (108 µg/ml) was used, and then two-fold serial dilutions were done using MHB to obtain the following dilutions: 54, 27, 13.5, 6.8, 3.4, 1.7, 0.8, 0.4, 0.2 and 0.1 µg/ml [11]. Quality control was performed using E. coli (ATCC 25,922) strain as a positive control.
The effect of the combination of ineffective antibiotics with AgNPs was evaluated by checkerboard method [12]. The mean MIC values obtained for the combinations were used for the calculation of the fractional inhibitory concentration (FIC) index.
FIC index was calculated using the following formula:
An average FIC was calculated from four FIC from each raw to classify the combined antibacterial effect of antibiotics and AgNPs as synergistic (FIC ≤ 0.5), additive (0.5 < FIC ≤ 1), indifferent (1 < FIC < 2) and antagonistic (FIC ≥ 2) [13].
Effect of AgNPs on beta-lactamases production was evaluated by DDST. AgNPs solution was added to liquid MHA to achieve a final silver concentration equal to MICAg/2.
MHA plate that contained AgNPs was inoculated with two loopful of bacterial suspension of ESBL producing E. coli and K. pneumoniae isolates (108 CFU/ml). Cefotaxime disc (30 µg) and ceftazidime (30 μg) were placed 15 mm apart (edge to edge) from an amoxicillin-clavulanic acid disc (20/10 μg). Then, plates were incubated for 16–20 h at 35 °C. A positive result was indicated when the inhibition zones around cefotaxime and ceftazidime discs were not augmented in the direction of the disc containing clavulanic acid (inhibition of enhancement) [11].
2.4 Statistical analysis of data
Data were collected and entered to the computer using Statistical Package for Social Science (SPSS) program for statistical analysis (version 21). Chi-square test (χ2) was used to test association between qualitative variables. Monte Carlo corrections were carried out when indicated (n × m table or expected cells less than 5). Fisher exact (FE) correction and correction for Chi-square were done when more than 20% of the cells have expected count less than 5. An alpha level was set to 5% with a significance level of 95%, and a beta error accepted up to 20% with a power of study of 80%.
3 Results
3.1 Synthesis and characterization of AgNPs
Silver nanoparticles colloidal solution (108 mg/l) was purchased from nanotech. Egypt company. Silver nanoparticles had been prepared by chemical reduction method, a solution of silver nitrate (AgNO3) had been used as Ag+ ions precursor, polyvinylpyrrolidone (PVP) had been used as stabilizing agent and sodium borohydride as mild reducing agent (Nanotech Egypt).
The particles diameter was confirmed by transmission electron microscopy (TEM) using the JEOL JEM-2100 (Jeol, Japan) high-resolution transmission electron microscope at an accelerating voltage of 200 kV, which showed a spherical like shape of the nanoparticles with an average size of 45 ± 5 nm as illustrated in Fig. 1. TEM determines shape and size in two-dimensional image formed from two electrons transmitted through the sample.
Hydrodynamic diameter, size distribution and zeta potential of silver nanoparticles were characterized by Malvern Zetasizer Nano ZS, as average diameter was recorded as 75 nm with narrow particles size distribution and zeta potential was recorded as − 11.0 Mv as shown in Figs. 2 and 3. Zeta potential is defined as net of particle surface charge in a dispersion medium. Measurement of zeta potential evaluates AgNPs dispersion and aggregation properties which affect stability in application. Different characterization methods are illustrated in Table 1.
3.2 Demographic characteristics of 43 patients with ESBL infections
Most of the patients were females, 29 (67.44%) out of 43, and the majority of them (48.28%) were above 51 years, this was followed by those aged from 31 to 50 years (31.03%). As regards male patients, 11 (78.58%) out of 14 males were in the age group above 51 years, while 2 (14.28%) of them were in the age group from 16 to 30 years (χ2 (df=2) = 13.250* p(MC) = 0.002*).
3.2.1 Distribution of ESBL infections according to site of infections
The majority of ESBL infections, 36 (83.72%) out of 43 were UTIs, while 4 (9.30%) were infections from burns and 3 (6.98%) were skin wound infections (χ2(df=2) = 1.740 P = 0.548). Most of UTIs (91.67%) were due to ESBL E. coli, while most the burn infections (75.00%) and surgical wound infections (66.67%) were due to ESBL K. pneumoniae.
3.2.2 Distribution of community and hospital acquired ESBL infections
Out of 43 ESBL infections, 26 (60.47%) were hospital-acquired, while 17 (39.53%) were community-acquired. All CA-ESBL infections were UTIs, while 73.08% of HA-ESBL infections were UTIs, 15.38% were burn infections and 11.54% were wound infections (χ2(df=2) = 11.445 P = 0.003*).
3.2.3 Antimicrobial susceptibility patterns of 43 E. coli and K. pneumoniae
All E. coli isolates (100%) showed resistant MIC values for ampicillin and cefotaxime. About 91.43% and 82.86% of them had resistant MIC values for ceftazidime and ciprofloxacin, respectively. All K. pneumoniae isolates showed resistant MIC values for ampicillin and cefotaxime (100%). About 87.50% and 75.00% of them had resistant MIC values for ceftazidime and ciprofloxacin, respectively.
MIC value of AgNPs against 43 ESBL producing E. coli and K. pneumoniae isolates was 27 µg/ml. The calculated FIC indexes of AgNPs-ampicillin, AgNPs-cefotaxime, AgNPs-ceftazidime and AgNPs-ciprofloxacin combinations showed synergistic effects against 77.14%, 88.57%, 88.57% and 91.43% of ESBL producing E. coli, respectively. Moreover, these combinations were synergistic against 50.00%, 75.00%, 62.50% and 62.50% of ESBL producing K. pneumoniae, respectively, as illustrated in Table 2.
At MICAg/2, 85.71%, 91.43%, 88.57% and 91.43% of ESBL producing E. coli isolates showed sensitive MIC breakpoints to ampicillin, cefotaxime, ceftazidime and ciprofloxacin, respectively, as shown in Table 3.
At MICAg/2, 75.00%, 87.50%, 87.50% and 75.00% of ESBL producing K. pneumoniae isolates showed sensitive MIC breakpoints to ampicillin, cefotaxime, ceftazidime and ciprofloxacin, respectively, as illustrated in Table 4.
The production of beta-lactamases enzymes detected by DDST had been inhibited using AgNPs in 91.43% of E. coli and 75% of K. pneumoniae isolates as illustrated in Figs. 4 and 5.
4 Discussion
Female gender is a significant risk factor for ESBLs positivity. This association had been encountered in the present study, where 67.44% of patients with ESBL infections were females. Another significant risk factor of ESBL bacteria is advanced age, which may be linked to the presence of other comorbid conditions, overuse of broad-spectrum antibiotics and depressed immunity. In the present study, the majority of patients with ESBL infections (58.14%) was in an age group above 51 years. Infections caused by ESBL bacteria usually affect the urinary tract, lower respiratory tract, bloodstream, gastrointestinal and wounds [14]. In the present study, there was a significant predominance of UTIs, which constituted 36 (83.72%) out of 43 ESBL infections.
Broth microdilution assay was performed to determine the MIC values of four ineffective antibiotics; ampicillin, cefotaxime, ceftazidime and ciprofloxacin. ESBL producing E. coli isolates (n = 35) showed ampicillin MIC values ranging from 32 to 64 µg/ml. MIC values were recorded for cefotaxime, ceftazidime and ciprofloxacin antibiotics (8–32 µg/ml, 16–32 µg/ml and 32 µg/ml, respectively). ESBL producing K. pneumoniae isolates showed higher MIC values for ampicillin and cefotaxime, ceftazidime than ESBL producing E. coli (64 µg/ml, 32–64 µg/ml and 32–64 µg/ml, respectively). Ciprofloxacin resistance had increased in ESBL producers E. coli than K. pneumoniae strains. This observation had been investigated in the present study, and it was found that ESBL producing K. pneumoniae isolates had lower MIC values for ciprofloxacin than ESBL producing E. coli isolates (1–8 µg/ml). Unusual mutations in multiple antibiotic resistance (mar) locus or alteration in outer-membrane protein in ESBL-producing E. coli strains are potential explanations for the observed higher MIC value for ciprofloxacin [15, 16]. The results of the present study were following those reported by Panacek et al. from Czech Republic [11]. On the other hand, higher ampicillin MIC values (128 µg/ml) in E. coli isolates had been recorded by Lopez-Carrizales et al. from Mexico [17], which may be attributed to inclusion of only multi-drug resistant E. coli isolates from clinical samples in their study. Kang et al. from Korea [18] recorded far beyond MIC breakpoints for cefotaxime, ceftazidime and ciprofloxacin (128 µg/ml).
AgNPs are effective growth inhibitors of different microorganisms. In the present study, AgNPs had demonstrated antibacterial activity which was reflected by an average MIC value (MICAg = 27 µg/ml) against both ESBL producing E. coli and K. pneumoniae isolates. This may be attributed to the use of colloids AgNPs synthesized by chemical reduction method, stabilized and capped with PVP as they exhibit a narrow particle size distribution, higher stability between capping molecules and nanoparticle surfaces, and higher antibacterial effect. This result was comparable to those reported by Vazquez-Munoz et al. from Mexico (MIC = 10 µg/ml) [19] and Ansari et al. from India (MIC = 11.25–45 µg/ml) [20]. On the other hand, Kar et al. from India [21] reported high MIC values of AgNPs against MDR-ESBL producing E. coli from poultry origin (MIC50 = 172–218 mmol/L, MIC80 = 450–640 mmol/L) which may be due to the large particle size of AgNPs used in their study (100 nm). Shafreen et al. from India [22] found that AgNPs suspension synthesized by biological method lost their bactericidal effect in concentrations higher than 100 µg/ml.
AgNPs combinatorial strategies are initiatives of fighting antibiotic resistance. In the present study, All AgNPs-β-lactam antibiotics combinations had augmented the effects of ineffective antibiotics and lowered MIC values by several folds in all used AgNPs concentration. The greatest enhancement of the activity of antibiotics was observed at AgNPs concentrations (MICAg/2 and MIC Ag/4), as they lowered MIC values of ampicillin from 32 to 64 µg/ml to 4 µg/ml in 85.71% and 80.00% of E. coli isolates, respectively. These results were in agreement with the study of Singh et al. from India who found that the AgNPs-ampicillin combination lowered MIC of ampicillin from 8 to 0.125 µg/ml [23].
Klebsiella pneumoniae isolates usually show intrinsic resistance to ampicillin. AgNPs-ampicillin combination lowered MIC values of ampicillin from 64 to 8 µg/ml. About 75.00% and 62.5% of ESBL producing K. pneumoniae isolates became susceptible to ampicillin when combined with MICAg/2 and MICAg/4, respectively. This may be due to attachment of AgNPs-ampicillin combination to bacterial cell and DNA unwinding. These findings corroborate well with those reported by Sen et al. from India who found that the AgNPs-ampicillin combination had inhibited 100% of K. pneumoniae isolates that were originally resistant to ampicillin [24].
These results were comparable to those found by Panacek et al. who found that MICAg/8 was considered as the threshold concentration at which disappearance of the enhanced effect occurred, especially for multiresistant bacteria [11]. On the other hand, Vazquez-Munoz et al. disagreed with the enhanced effect of AgNPs-β-lactam antibiotics combinations, and they argued that the effects on β-lactam on cell wall integrity are not influenced by changes in cell permeability and antibiotic entry enhanced by AgNPs [19]. Negative DDST (no ESBLs production) was observed in 91.43% of ESBL producing E. coli and 75.00% ESBLs producing K. pneumoniae isolates. Enlargement of inhibition zones around all the antibiotic discs with no augmentation of zones toward amoxicillin–clavulanic disc suggested that the possible mechanism of action of AgNPs is obstructing β-lactamase activity not hydrolyzing the antibiotics, thus the restoration of the antibacterial activity of the antibiotics. Similar results were reported by Panacek et al. [11].
The four combinations showed additive effects against some ESBL isolates. It is worth noting that these isolates were acquired from the hospitals, not community infections which usually showed higher antibiotic resistance patterns. FIC index was indifferent in AgNPs-ampicillin combination in only 3 isolates (6.98%) out of 43 isolates, one was ESBL producing E. coli, and two were ESBL producing K. pneumoniae. This may be attributed to the resistant profiles of these isolates as they were carbapenem-resistant.
The limitation of the present study was the limited sample size and inclusion of only E. coli and K. pneumoniae isolates. The present study recommends use of AgNPs combinations with different ineffective antibiotic classes as a valuable alternative to combat drug resistance, with the need to further studies to determine the in-vivo activity of AgNPs on different species of ESBL Enterobacteriaceae.
5 Conclusions
The highest synergistic combination against ESBL E. coli isolates was that of ciprofloxacin with AgNPs followed by cefotaxime and ceftazidime. As regards ESBL K. pneumoniae isolates, a combination of AgNPs with cefotaxime was the highest followed by ceftazidime and ciprofloxacin. The least synergistic combination against all studied isolates was that of AgNPs and ampicillin. MICAg/8 and MICAg/16 concentrations decreased MIC values of antibiotics but never fell below sensitive breakpoints. AgNPs inhibited the production of beta-lactamase enzymes.
Availability of data and materials
All datasets on which the conclusions of the manuscript rely with all authors in excel sheets and to be presented the journal if needed.
Abbreviations
- AMUH:
-
Alexandria Main University Hospital
- AgNPs:
-
Silver nanoparticles
- CLED:
-
Cysteine lactose electrolyte deficient agar
- DDST:
-
Double disc synergy test
- DNA:
-
Deoxyribonucleic acid
- E. coli :
-
Escherichia coli
- ESBL:
-
Extended spectrum beta-lactamases
- FIC:
-
Fractional inhibitory concentration
- K. pneumonia :
-
Klebsiella Pneumoniae
- MIC:
-
Minimum inhibitory concentration
- MICAg:
-
Silver minimum inhibitory concentration
- MDR:
-
Multi-drug resistance
- NPs:
-
Nanoparticles
- PVP:
-
Polyvinylpyrrolidone
- TEM:
-
Transmission electron microscopy
References
Maina D, Makau P, Nyerere A, Revathi G (2013) Antimicrobial resistance patterns in extended-spectrum β-lactamase producing Escherichia coli and Klebsiella pneumoniae isolates in a private tertiary hospital. Kenya Microbiol Dis. https://doi.org/10.7243/2052-6180-1-5
Huh A, Kwon YJ (2011) “Nanoantibiotics”: a new paradigm for treating infectious diseases using nanomaterials in the antibiotics resistant era. J Cont Rel 156(2):128–145. https://doi.org/10.1016/j.jconrel.2011.07.002
Castillo RR, Lozano D, González B, Manzano M, Izquierdo-Barba I, Vallet-Regí M (2019) Advances in mesoporous silica nanoparticles for targeted stimuli-responsive drug delivery: an update. Exp Opin Drug Del 16:415–439. https://doi.org/10.1080/17425247.2019.1598375
Vallet-Regí M, González B, Izquierdo-Barba I (2019) Nanomaterials as promising alternative in the infection treatment. Int J Mol Sci 20(15):3806. https://doi.org/10.3390/ijms20153806
Deng H, McShan D, Zhang Y, Sinha SS, Arslan Z, Ray PC, Yu H (2016) Mechanistic study of the synergistic antibacterial activity of combined silver nanoparticles and common antibiotics. Environ Sci Technol 50(16):8840–8848. https://doi.org/10.1021/acs.est.6b00998
Fayaz AM, Balaji K, Girilal M, Yadav R, Kalaichelvan PT, Venketesan R (2010) Biogenic synthesis of silver nanoparticles and their synergistic effect with antibiotics: a study against gram-positive and gram-negative bacteria. Nanomed Nanotechnol Biol Med 6(1):103–109. https://doi.org/10.1016/j.nano.2009.04.006
De Souza A, Mehta D, Leavitt RW (2006) Bactericidal activity of combinations of Silver-Water Dispersion™ with 19 antibiotics against seven microbial strains. Curr Sci 91(7):926–929
Tille P (2013) Baily & Scott's diagnostic microbiology, 13th edn. Elsevier Health Sciences. https://www.elsevier.com/books/bailey-and-scotts-diagnostic-microbiology/tille/978-0-323-08330-0
Wayne P (2020) Clinical and laboratory standards institute. Performance standards for antimicrobial susceptibility testing, National Committee for Clinical Laboratory. https://community.clsi.org/media/3481/m100ed30_sample.pdf
Wiegand I, Hilpert K, Hancock REW (2008) Agar and broth dilution methods to determine the minimal inhibitory concentration (MIC) of antimicrobial substances. Nat Protocols 3(2):163–175. https://doi.org/10.1038/nprot.2007.521
Panáček A, Smékalová M, Večeřová R, Bogdanová K, Röderová M, Kolář M et al (2016) Silver nanoparticles strongly enhance and restore bactericidal activity of inactive antibiotics against multiresistant Enterobacteriaceae. Colloids Surf B Biointerfaces 142:392–399. https://doi.org/10.1016/j.colsurfb.2016.03.007
Schwalbe R, Steele-Moore L, Goodwin AC (2007) Antimicrobial susceptibility testing protocols, 1st edn. CRC Press, New York
European Committee on Antimicrobial Susceptibility Testing [EUCAST] (2019) Breakpoint tables for interpretation of MICs and zone diameters. Version 9.0. https://eucast.org/clinical_breakpoints/
Al-Garni SM, Ghonaim MM, Ahmed MMM, Al-Ghamdi AS, Ganai FA (2018) Risk factors and molecular features of extended-spectrum beta-lactamase producing bacteria at southwest of Saudi Arabia. Saudi Med J 39(12):1186–1194. https://doi.org/10.15537/smj.2018.12.23273
Ghadiri K, Akya A, Elahi A, Jafari S, Chegenelorestani R (2019) Evaluation of resistance to ciprofloxacin and identification of mutations in topoisomerase genes in Escherichia coli and Klebsiella pneumonia isolated from pediatric urinary tract infections. J Pediatr Res 6(4):322–328. https://doi.org/10.4274/jpr.galenos.2019.16362
Tolun V, Küçükbasmaci Ö, Törümküney-Akbulut D, Çatal Ç, Anğ-Küçüker M, Auğ Ö (2004) Relationship between ciprofloxacin resistance and extended-spectrum β-lactamase production in Escherichia coli and Klebsiella pneumoniae strains. Clin Microbiol Infect 10(1):72–75. https://doi.org/10.1111/j.1469-0691.2004.00723.x
Lopez-Carrizales M, Velasco KI, Castillo C, Flores A, Magaña M, Martinez-Castanon GA et al (2018) In vitro synergism of silver nanoparticles with antibiotics as an alternative treatment in multiresistant uropathogens. Antibiotic (Basel, Switzerland) 7(2):50. https://doi.org/10.3390/antibiotics7020050
Kang CI, Wi YM, Lee MY, Ko KS, Chung DR, Peck KR, Lee NY, Song JH (2012) Epidemiology and risk factors of community onset infections caused by extended-spectrum β-lactamase-producing Escherichia coli strains. J Clin Microbiol 50(2):312–317. https://doi.org/10.1128/jcm.06002-11
Vazquez-Muñoz R, Meza-Villezcas A, Fournier PGJ, Soria-Castro E, Juarez-Moreno K, Gallego-Hernández AL et al (2019) Enhancement of antibiotics antimicrobial activity due to the silver nanoparticles impact on the cell membrane. PLoS ONE 14(11):e0224904. https://doi.org/10.1371/journal.pone.0224904
Ansari MA, Khan HM, Khan AA, Cameotra SS, Pal R (2014) Antibiofilm efficacy of silver nanoparticles against biofilm of extended spectrum β-lactamase isolates of Escherichia coli and Klebsiella pneumoniae. Appl Nanosci 4(7):859–868. https://doi.org/10.1007/s13204-013-0266-1
Kar D, Bandyopadhyay S, Dimri U, Mondal DB, Nanda PK, Das AK, Batabyal S, Dandapat P, Bandyopadhyay S (2016) Antibacterial effect of silver nanoparticles and capsaicin against MDR-ESBL producing Escherichia coli: an in-vitro study. Asian Pacific J Trop Dis 6(10):807–810. https://doi.org/10.1016/S2222-1808(16)61135-0
Shafreen RB, Seema S, Ahamed AP, Thajuddin N, Alharbi SA (2017) Inhibitory effect of biosynthesized silver nanoparticles from extract of Nitzschia palea against curli-mediated biofilm of Escherichia coli. Appl Biochem Biotechnol 183(4):1351–1361. https://doi.org/10.1007/s12010-017-2503-7
Singh R, Wagh P, Wadhwani S, Gaidhani S, Kumbhar A, Bellare J, Chopade BA (2013) Synthesis, optimization, and characterization of silver nanoparticles from Acinetobacter calcoaceticus and their enhanced antibacterial activity when combined with antibiotics. Int J Nanomed 8:4277–4290. https://doi.org/10.2147/IJN.S48913
Sen IK, Mandal AK, Chakraborti S, Dey B, Chakraborty R, Islam SS (2013) Green synthesis of silver nanoparticles using glucan from mushroom and study of antibacterial activity. Int J Biol Macromol 62:439–449. https://doi.org/10.1016/j.ijbiomac.2013.09.019
Acknowledgements
High Institute of Public Health (Microbiology Department) staff members.
Funding
Not applicable.
Author information
Authors and Affiliations
Contributions
MIM: participated in approval of the final version of manuscript. FZA: participated in the design of the study. NFAEMA: interpretation of laboratory results and statistical analysis of data, drafting of manuscript. ASAM: implementation of laboratory investigation and acquisition of data. All authors have read and approved the manuscript.
Corresponding author
Ethics declarations
Ethics approval and consent to participate
The study was approved by the Ethics Committee of the High Institute of Public Health (HIPH) for conducting the research and the administrative approval of Alexandria Main University Hospital (AMUH). The researchers complied with the International Guidelines for Research Ethics. A written approval from patients admitted to AMUH after explanation of the purpose and benefits of the research.
Consent for publication
Not applicable.
Competing interests
All authors declare that they have no conflict of interest.
Additional information
Publisher's Note
Springer Nature remains neutral with regard to jurisdictional claims in published maps and institutional affiliations.
Rights and permissions
Open Access This article is licensed under a Creative Commons Attribution 4.0 International License, which permits use, sharing, adaptation, distribution and reproduction in any medium or format, as long as you give appropriate credit to the original author(s) and the source, provide a link to the Creative Commons licence, and indicate if changes were made. The images or other third party material in this article are included in the article's Creative Commons licence, unless indicated otherwise in a credit line to the material. If material is not included in the article's Creative Commons licence and your intended use is not permitted by statutory regulation or exceeds the permitted use, you will need to obtain permission directly from the copyright holder. To view a copy of this licence, visit http://creativecommons.org/licenses/by/4.0/.
About this article
Cite this article
Mohammed, A.S.A., Mourad, M.I., Alsewy, F.Z. et al. Combination of silver nanoparticles with ineffective antibiotics against extended spectrum beta-lactamases producing isolates at Alexandria Main University Hospital, Egypt. Beni-Suef Univ J Basic Appl Sci 10, 58 (2021). https://doi.org/10.1186/s43088-021-00147-2
Received:
Accepted:
Published:
DOI: https://doi.org/10.1186/s43088-021-00147-2